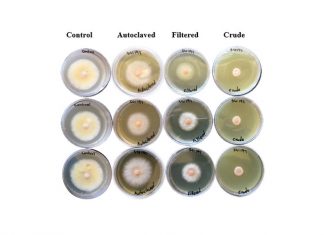
Nematodes as potential biofungicide for Fusarium head blight

Proewe bevorder volhoubaarheid van sorghum
Graan SA se sorghumkultivarproefprojek is in sy sesde seisoen. Die projek vind plaas in samewerking met die sorghumsaadmaatskappye (Agricol, Limagrain Zaad, Corteva en AGT Foods Africa) en produsente. Die doel van die projek is...
Riglyne vir produsente wat eerste keer sojabone plant
Wanneer ’n produsent besluit om sojabone te begin produseer, moet dit twee jaar voor die werklike plant daarvan plaasvind, aangesien sekere faktore eers in plek moet wees alvorens geplant kan word.
Die belangrikste faktor is...
Kombinasie van metodes nodig om onkruid te beheer
Normaalweg is daar ’n wye verskeidenheid onkruide teenwoordig in sojaboonaanplantings met die intensiteit van voorkoms wat kan varieer. Aangesien die verskillende onkruidspesies, veral gras- en breëblaaronkruide, verder verskil wat betref groeiproses en lewensiklus, is...
Climatic conditions can impact false armyworm outbreaks
Since false armyworm was never a serious pest in South Africa, moth flight activity was not monitored prior to the first outbreak in 2010. Therefore, it was decided to look at the rainfall pattern...
Nematodes – a semi-commercial farmer’s microscopic enemy
Maize is an important cereal crop used as a food source for humans and animals in most parts of the world. Global production exceeds 600 million metric tons, with about 60% produced in developing...
Palmer amarant en die cara-wet
Sedert Palmer amarant (Amaranthus palmeri) gedurende 2018 vir die eerste keer in Suid-Afrika in die Noord-Kaap in mielie-, katoen- en alfalfalande in die Douglas-omgewing opgemerk is, het verskeie plantbeskermingsmaatskappye asook navorsings- en landboukundige instansies...
Nematodes as potential biofungicide for Fusarium head blight
The underlying principle of integrated pest management (IPM) is based on minimising the use of chemical pesticides as these can be a threat to ecosystems and an expense to the economy.
An alternative strategy that...
Keeping an eye on increasing wheat rust incursions
Exotic wheat rust incursions have significantly increased in South Africa in recent years. Therefore, ongoing rust surveillance conducted by ARC-Small Grain should be strengthened and supported as it will aid in the early detection...
RWA present in all SA wheat production areas
The invasive ability of an insect in a specific area will be determined by establishment success and rate of spread, but also by environmental factors that will influence the adaptation and spread within the...
Probleme onder onkruid se enjinkap
Hoe is dit moontlik dat so ’n klein bietjie onkruiddoder die vermoë besit om ’n hele onkruidplant dood te maak? Onmiddellik het hierdie vraag my teruggeneem na my prille jeug en Bethlehem se winters…
Ek...